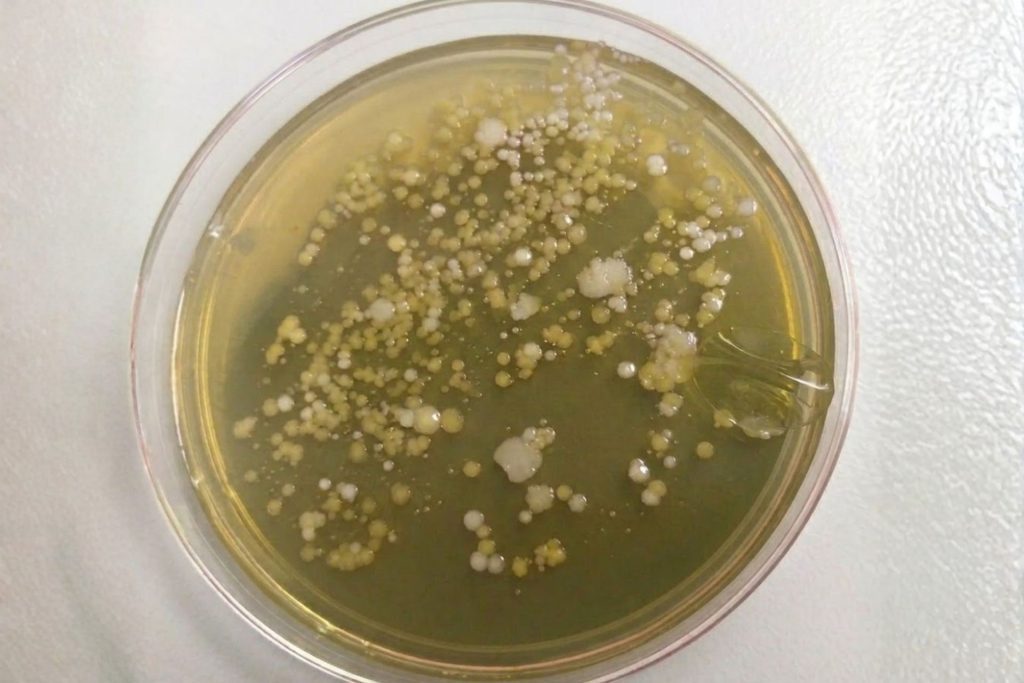
Petri dish

Has your contact lens dried out? Maybe you left your contacts in their case but forgot to add the solution. Or, perhaps you accidentally left it sitting on the side of your sink.
So, if your contact lens dried out, can you bring it back to life?
That depends on how the lens dried out and what kind of contact it is. There are a few situations where you might be able to salvage your lens. But in most cases, it’s simply not worth the risk.
This guide will explain what happens when you let a contact lens dry out, and how to decide what you should do next.
What Happens When a Contact Lens Dries Out?
Contact lenses are made from soft materials that need moisture to maintain their flexibility and shape. If a lens is dry, it means water has evaporated out of the material. This will cause it to shrink and become less flexible, affecting how the contact sits and moves on your eye.
If you put your dried-out lens back into some contact solution, it will reabsorb moisture. But this doesn’t necessarily mean it will be safe to wear.
Even once rehydrated, the lens may not return to its original form or structure. The surface can also develop irregularities, and sometimes these can be so small that they can only be seen under a microscope.
Risk of contamination
You also need to think about the risk of contamination, both from the surface you left the contact on and even from your own eye.
If you accidentally leave your lens on a bathroom surface, like the sink, bacteria could become a big concern. In fact, if you leave a lens anywhere except safely inside the case, the risk of bacteria and dust attaching to the lens becomes very high.
A dried-out contact is even at risk of being contaminated by the natural proteins and lipids present in your own tears. As the lens dries, minerals from your tears can create hard white spots on the lens. These spots can irritate your eye even after you rehydrate the lens.
Damage or contamination of your contacts isn’t always visible, but it can still affect your eye health.
Can You Reuse a Dried-Out Contact?
Sometimes… but only in a specific scenario.
If you briefly left your lenses in their case without solution (and that case was clean and closed), there’s a chance you could rehydrate them again and wear them.
If a lens dried out anywhere else besides your case, it’s really best not to risk it. Even if it looks fine, there’s just no way for you to know what kind of contaminants or bacteria it picked up from the surface and environment.
You should also only ever think about reusing a dried-out lens if it’s a reusable lens. Monthly or weekly contacts are designed to be reused, but daily contacts should never be reinserted once you’ve removed them.
When It Might Be Safe To Reuse a Dried Lens

Here’s what needs to have happened before you even consider trying to reuse a contact lens.
- It dried out in a clean, closed contact lens case.
- The time the lens spent out of solution was brief (15–30 minutes).
- It’s a reusable lens, like a monthly contact.
- It returns to its normal shape after soaking.
Even if all of this is true, you should still be cautious. If anything about the lens looks or feels wrong, it’s better to just throw it away.
When You Should Throw Contact Lenses Away
There are plenty of situations where a dried-out lens isn’t worth saving.
- It’s a daily disposable lens.
- It dried out on a surface like a sink or counter.
- It looks warped or cloudy.
- It feels uncomfortable to wear even after rehydrating.
- You’re not sure how long it’s been sitting out.
If you’re even a little bit hesitant to reuse a contact, it’s safer to replace the lens with a fresh one. Your eye health is more important than saving one or two dried-out contact lenses.
How To Rehydrate a Contact Lens Safely

If you decide to try saving a lens, you need to rehydrate it properly.
Start by putting the lens in fresh contact solution. Never use water. Let it soak for a few hours so it can fully absorb the solution and become fully hydrated again.
Once it’s rehydrated, check the shape to confirm the surface is smooth and that it holds its normal curve. Before putting it in your eye, give it a quick rinse with contact solution.
If it doesn’t look right or feels uncomfortable at any point, don’t wear it.
Risks of Wearing a Dried-Out Contact Lens
Wearing a dried-out lens can lead to a few problems, even if it seems fine at first.
A lens that has lost its shape can cause irritation or a “gritty” feeling. If it doesn’t sit properly on your eye, it can stop correcting your vision as well as it did before, too.
There’s also a higher risk of contamination. If bacteria or debris are on the lens, wearing it could lead to irritation or even an eye infection.
You’ll have to weigh up these risks and decide if saving your contact is really worth it.
How To Prevent Contacts From Drying Out

There are a few very simple things you can do to prevent your contacts from drying out in the first place. These tips don’t only prevent drying out. They also help ensure the lenses stay clean and reduce the risk of contamination.
- Always store lenses in fresh solution (don’t reuse it).
- Make sure your case is closed properly.
- Don’t leave lenses out when you clean the case.
- Replace your contact lens case regularly (every one to three months is recommended).
TL;DR
- A dried-out contact lens is not always safe to reuse.
- Daily lenses should always be thrown away straight after you remove them.
- Monthly or weekly lenses may be salvageable if you leave them in a closed case without solution for less than 30 minutes.
- Only rehydrate lenses using contact solution, never water.
- If something looks or feels different about the lens, don’t wear it. It’s not worth risking your eye health.














